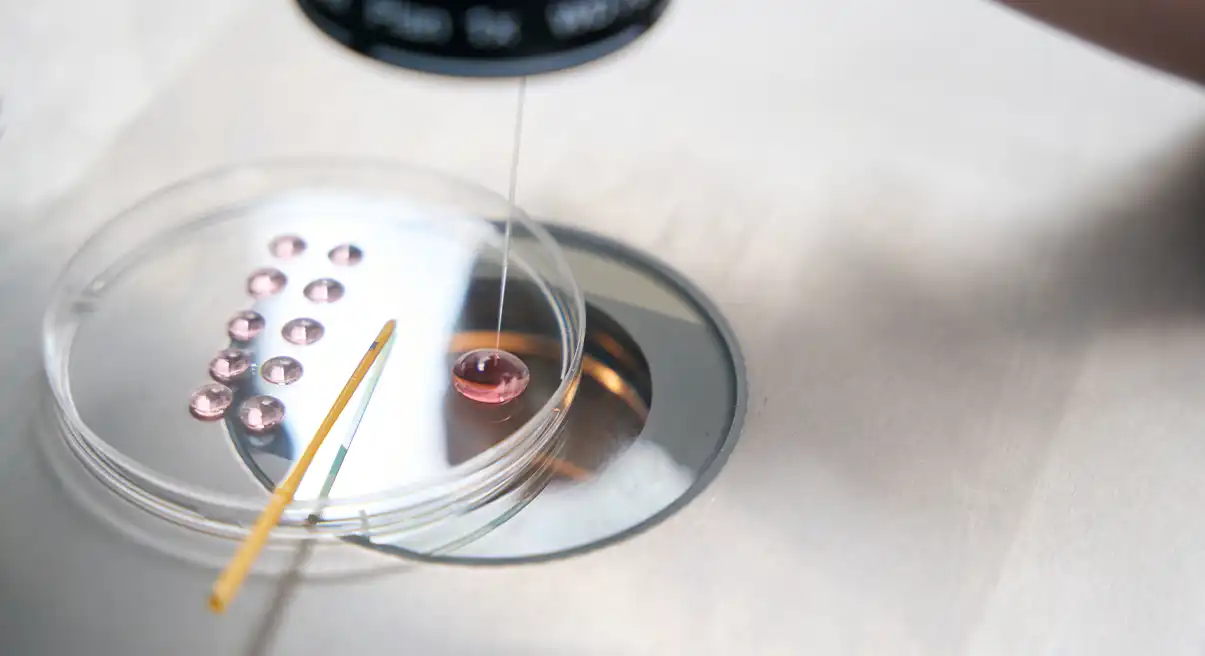
stem cell research

“May I also point out, in the face of the frequently unjust accusations of insensitivity addressed to the Church, her constant support for research dedicated to the cure of diseases and to the good of humanity throughout her 2,000-year-old history. If there has been resistance – and if there still is – it was and is to those forms of research that provide for the planned suppression of human beings who already exist, even if they have not yet been born. Research, in such cases, irrespective of efficacious therapeutic results is not truly at the service of humanity.”
—Pope Benedict XVI, “Stem Cells: What Future for Therapy?” 2006
Embryonic Stem Cell research (ESCR) involves harvesting human embryos (usually discarded embryos from IVF clinics) for their stem cells, the primordial cells in their body that have the potential to change into any other kind of cell (such as bone, muscle, or nerve, etc.) that could be used to repair damaged cells in a sick patient (such as turning stem cells into nerve cells and repair a patients damaged spine). However, the process used to extract these cells kills the human embryo in the process and therefore cannot be tolerated in a just society. Finally, along with obtaining stem cells from umbilical cord blood and other licit sources, scientists are discovering that they can create stem cells by taking adult skin cells and “reprogramming them” to act like totipotent embryos so that no real embryos need to be harmed or killed.
Human cloning, or Somatic Cell Nuclear Transfer (SCNT), is a process where a person’s genetic code (DNA) is placed in an empty human ovum. By stimulating the ovum with electricity, scientists can create an identical genetic copy of the human being from whom the DNA was taken. If this embryo that is created in a lab is implanted a woman’s womb, it may develop into a fully developed copy of the donor human being. Needless to say, human cloning is an affront to the dignity of the human person because it robs the clone, who is created of a loving father and mother, makes them the end result of a manufacturing process, and degrades their value in society’s eyes to that of their likeness to the original clone. Furthermore, cloned animals (such as sheep) tend top be extremely unhealthy.
In order to ensure the dignity of the human person embryonic stem cell research and human cloning must be opposed with the same vigor that we oppose abortion, euthanasia, and all other offenses against human life. The 2008 Vatican document Dignitatis Personae summarized the situation in this way, “To create embryos with the intention of destroying them, even with the intention of helping the sick, is completely incompatible with human dignity, because it makes the existence of a human being at the embryonic stage nothing more than a means to be used and destroyed. It is gravely immoral to sacrifice a human life for therapeutic ends.” (30)
Q: But shouldn’t we use discarded embryos that are going to die anyways in order to help find cures for sick people?
“Before I formed you in the womb I knew you, before you were born I dedicated you, a prophet to the nations I appointed you.”
—Jeremiah 1:5
A: It is a tragedy that any human being will be “thrown away” and that there is no licit means to remedy the situation. However, this does not give us a license to compound the situation by using these human beings bodies as avenues for medical experiments. Instead, these human beings should be granted a dignified death and no more embryonic human beings should be created. The situation could be likened to the plight of starving children in the third world who may “die anyways” because of our inability to provide them foreign aid. This tragic situation would certainly not justify us using these children for medical experiments and then discarding them in medical waste bins.
Dignitatis Personae approached this question and said in response:
With regard to the large number of frozen embryos already in existence the question becomes: what to do with them? Some of those who pose this question do not grasp its ethical nature, motivated as they are by laws in some countries that require cryopreservation centers to empty their storage tanks periodically. Others, however, are aware that a grave injustice has been perpetrated and wonder how best to respond to the duty of resolving it.
Proposals to use these embryos for research or for the treatment of disease are obviously unacceptable because they treat the embryos as mere “biological material” and result in their destruction. The proposal to thaw such embryos without reactivating them and use them for research, as if they were normal cadavers, is also unacceptable. (19)